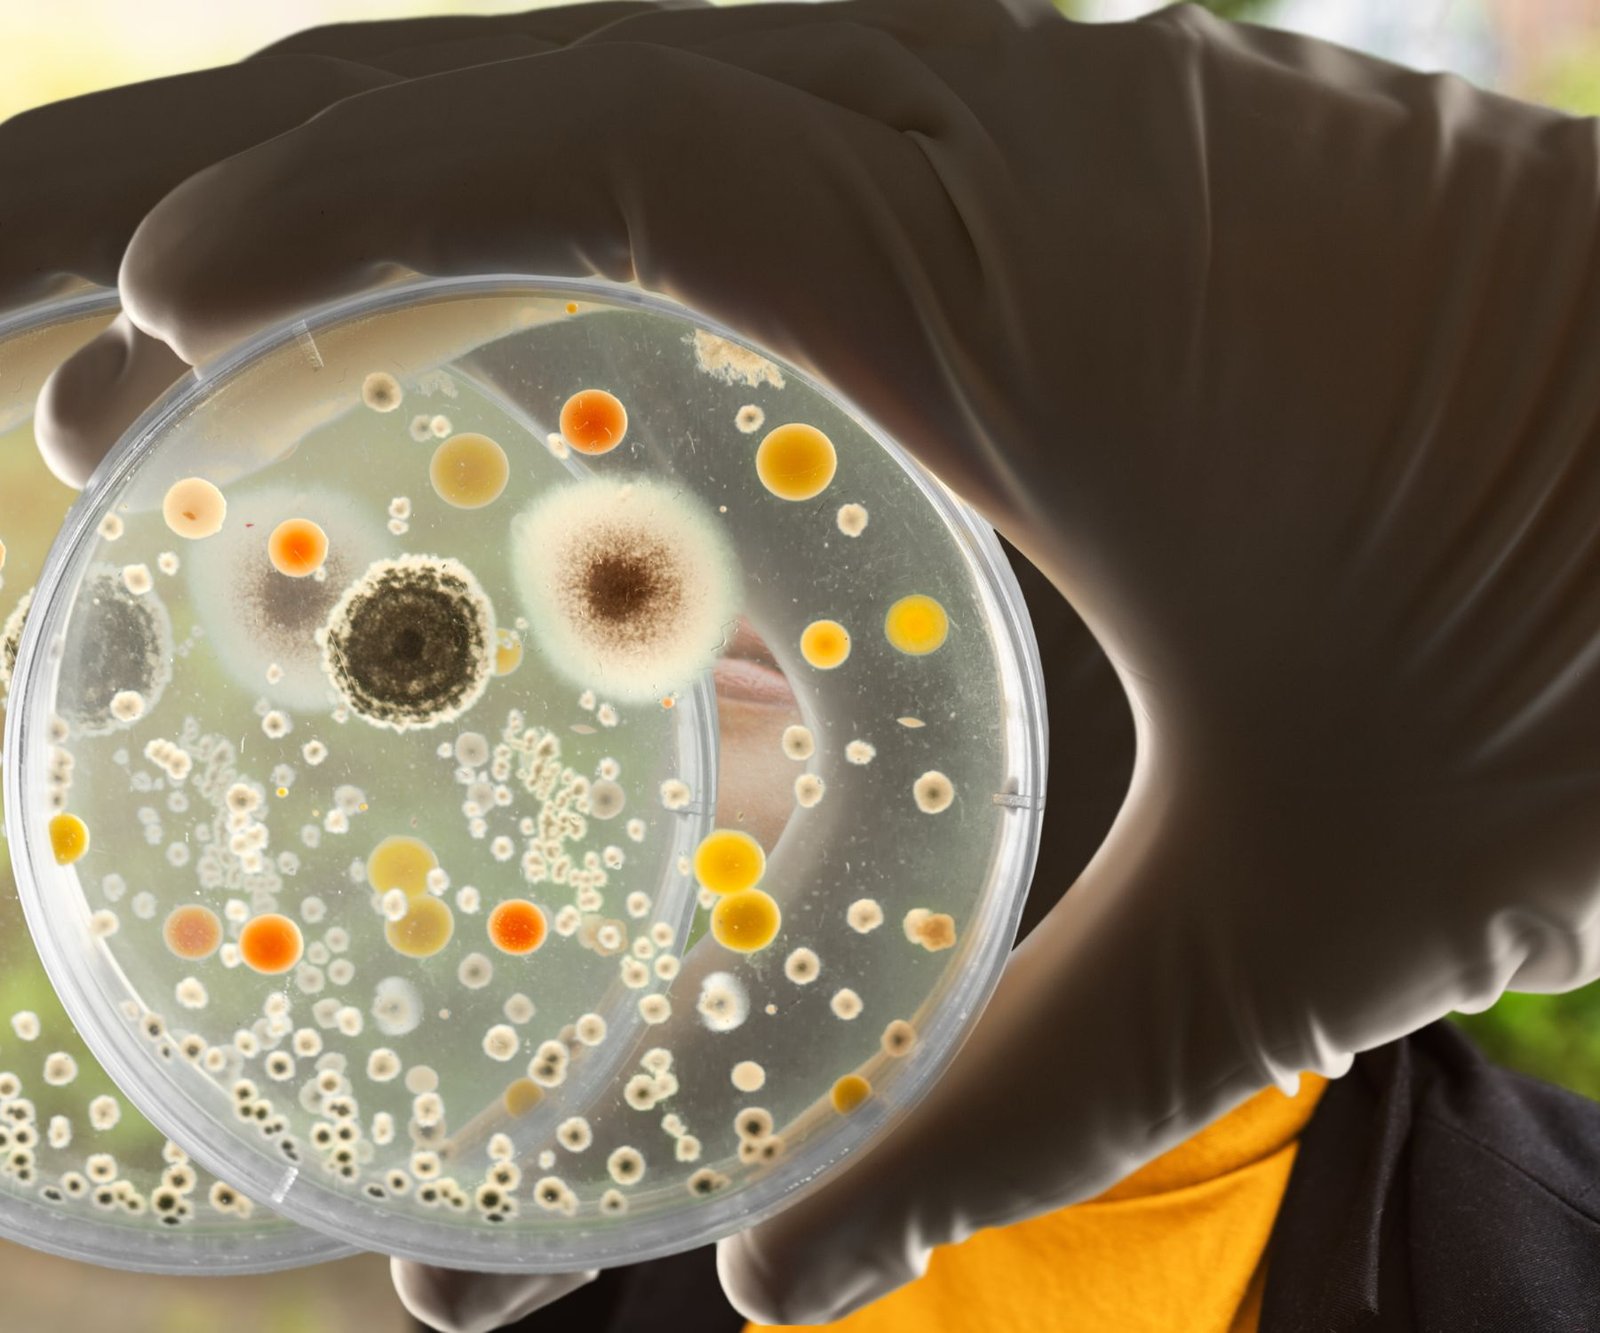

Best HEPA Air Purifiers for Removing Smoke in 2023
Air Purifiers,All Posts Choosing the Best HEPA Filters for Smoke Introduction HEPA filters are an effective way...

Benefits of a Humidifier While Sleeping (next to snoring train)
All Posts,HumidifiersSo how much of our lives do we spend sleeping, do they say? Like 26...

Bathroom Dehumidifier – What are the Best Options?
All Posts,DehumidifiersBathrooms are typically one of the most humid rooms in the house. And it’s no...

Basement Window Air Conditioning- What are the Options?
Air Conditioning,All PostsSolutions for Basement window air conditioning Basement air conditioning options include portable AC units, window...

Baby Humidifier (Benefits -Best Features)
Humidifiers,All PostsHaving a new baby in the house is one of the most exciting times that...

Are There Any Health Risks Associated With Using a Humidifier?
Humidifiers,All PostsAre there any health risks associated with using a humidifier? Yes, there are some potential...

Are There Any Disadvantages to Using a Humidifier?
Humidifiers,All PostsAre There Any Disadvantages to Using a Humidifier? In short, yes there can be some...
Are Space Heaters Expensive to Run?
Heating,All PostsHeating and cooling are easily the most expensive items on your utility bill. If you...

Related Posts:
- What Does Ozone Smell Like In An Air Purifier?
- Can Humidifiers Cause Mold?- The Answer May Surprise You
- Hydrogen Peroxide in Humidifier - What's the Controversy?
- Is a Humidifier a Cure for Asthma? (click bait alert)
- Can a Humidifier Make you Sick? (A Better Question is When?)
- What Does a Diffuser Do in a Room?

